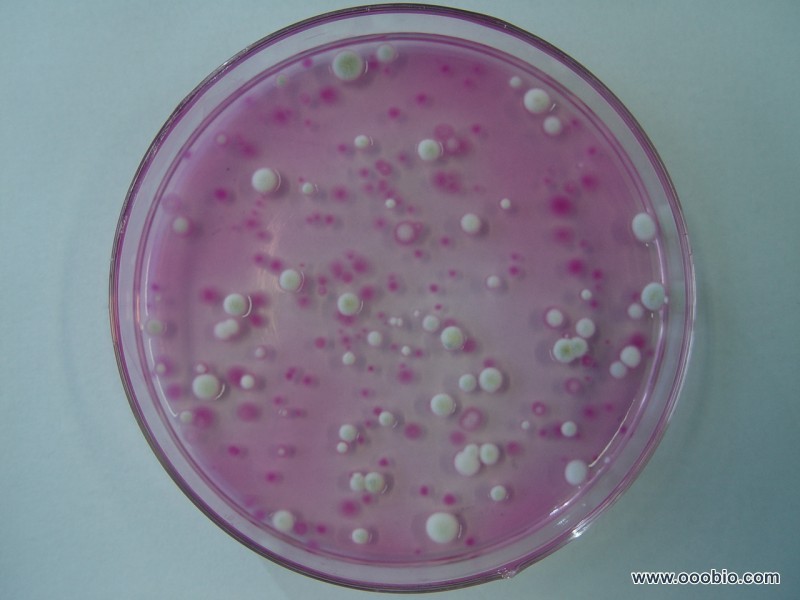

实验原理
霉菌菌丝较粗大,细胞易收缩变形,而且孢子很容易飞散,所以制标本时常用乳酸石炭酸棉蓝染色液。此染色液制成的霉菌标本片其特点是:(a)细胞不变形;(b)具有杀菌防腐作用,且不易干燥,能保持较长时间;(c)溶液本身呈蓝色,有一定染色效果。
霉菌自然生长状态下的形态,常用载玻片观察,此法是接种霉菌孢子于载玻片上的适宜培养基上,培养后用显微镜观察。此外,为了得到清晰、完整、保持自然状态的霉菌形态还可利用玻璃纸透析培养法进行观察。此法是利用玻璃纸的半透膜特性及透光性,将霉菌生长在覆盖于琼脂培养基表面的玻璃纸上,然后将长菌的玻璃纸剪取一小片,贴放在载玻片上用显微镜观察。
实验试剂
乳酸石炭酸棉蓝染色液,20%甘油,查氏培养基平板,马铃薯培养基;
实验设备
无菌吸管,载玻片,盖玻片,U形棒,解剖刀,玻璃纸,滤纸等。
实验材料
曲霉(Aspergillussp.),青霉(Penicilliumsp.),根霉(Rhizopussp.),毛霉(Mucorsp.);
实验步骤
1.一般观察法
于洁净载玻片上,滴一滴乳酸石炭酸棉蓝染色液,用解剖针从霉菌菌落的边缘处取小量带有孢子的菌丝置染色液中,再细心地将菌丝挑散开,然后小心地盖上盖玻片,注意不要产生气泡。置显微镜下先用低倍镜观察,必要时再换高倍镜。
2.载玻片观察法
(1)将略小于培养皿底内径的滤纸放入皿内,再放上U形玻棒,其上放一洁净的载玻片,然后将二个盖玻片分别斜立在载玻片的两端,盖上皿盖,把数套(根据需要而定)如此装置的培养皿叠起,包扎好,用1.05kg/cm2,121.3℃灭菌20分钟或干热灭菌,备用。
(2)将6—7ml灭菌的马铃薯葡萄糖培养基倒入直径为9cm的灭菌平皿中,待凝固后,用无菌解剖刀切成0.5—1cm2的琼脂块,用刀尖铲起琼脂块放在已灭菌的培养皿内的载玻片上,每片上放置2块。
(3)用灭菌的尖细接种针或装有柄的缝衣针,取(肉眼方能看见的)一点霉菌孢子,轻轻点在琼脂块的边缘上,用无菌镊子夹着立在载玻片旁的盖玻片盖在琼脂块上,再盖上皿盖。
(4)在培养皿的滤纸上,加无菌的20%甘油数毫升,至滤纸湿润即可停加。将培养皿置28℃培养一定时间后,取出载玻片置显微镜下观察。
3.玻璃纸透析培养观察法
(1)向霉菌斜面试管中加入5ml无菌水,洗下孢子,制成孢子悬液。
(2)用无菌镊子将已灭菌的、直径与培养皿相同的圆形玻璃纸覆盖于查氏培养基平板上。
(3)用1ml无菌吸管吸取0.2ml孢子悬液于上述玻璃纸平板上,并用无菌玻璃刮棒涂抹均匀。
(4)置28℃温室培养48小时后,取出培养皿,打开皿盖,用镊子将玻璃纸与培养基分开,再用剪刀剪取一小片玻璃纸置载玻片上,用显微镜观察。
- 上一篇:全球变暖可能致主要农作物减产
- 下一篇:酶制剂
